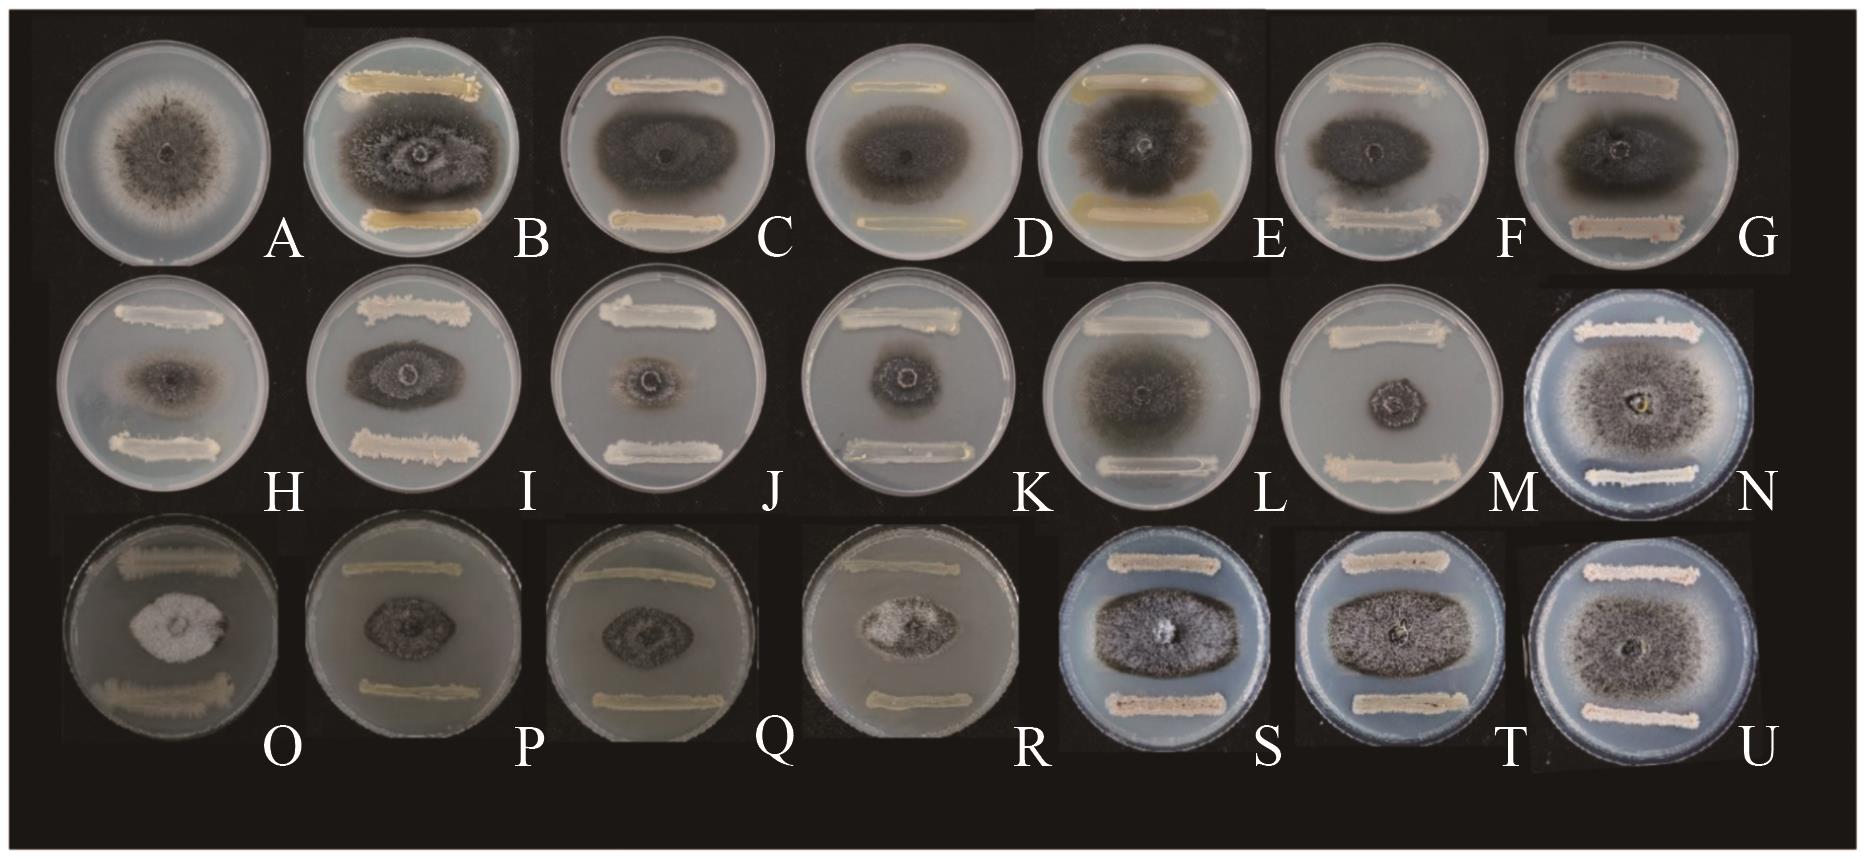
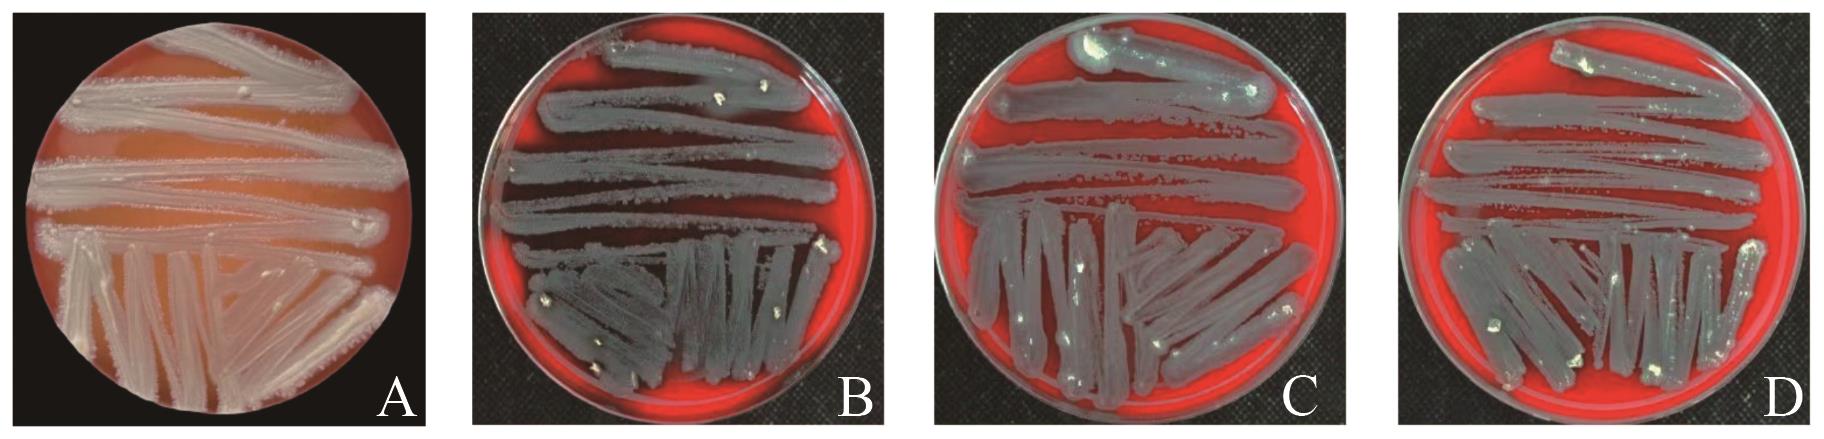

生物技术通报 ›› 2025, Vol. 41 ›› Issue (12): 313-327.doi: 10.13560/j.cnki.biotech.bull.1985.2025-0209
罗明凯( ), 张豪杰, 石晖琴, 李亚楠, 封瑞超, 沈硕(
), 张豪杰, 石晖琴, 李亚楠, 封瑞超, 沈硕( )
)
收稿日期:2025-02-27
出版日期:2025-12-26
发布日期:2026-01-06
通讯作者:
沈硕,女,博士,教授,研究方向 :生物防治;E-mail: fjfzss@126.com作者简介:罗明凯,男,硕士研究生,研究方向 :生物防治;E-mail: kailuo1010@163.com
基金资助:
LUO Ming-kai( ), ZHANG Hao-jie, SHI Hui-qin, LI Ya-nan, FENG Rui-chao, SHEN Shuo(
), ZHANG Hao-jie, SHI Hui-qin, LI Ya-nan, FENG Rui-chao, SHEN Shuo( )
)
Received:2025-02-27
Published:2025-12-26
Online:2026-01-06
摘要:
目的 马铃薯炭疽病由球炭疽菌(Colletotrichum coccodes)引起,严重影响产量品质,而芽胞杆菌(Bacillus spp.)是一类常见的生防菌,寻找高效低毒生防菌防治马铃薯炭疽病意义重大。本研究以3株高抑菌活性芽胞杆菌及其复合菌群为对象,旨在通过优化复合芽胞杆菌发酵参数,以提高其对该病菌抑菌活性,为研制复合生防菌剂提供参考。 方法 通过组织分离法和划线法从马铃薯块茎中分离内生菌,通过药敏纸片法筛选对马铃薯炭疽病具有较强抑制作用的菌株,结合形态学和分子生物学鉴定确定活性菌株的分类地位,通过药敏纸片法确定3株菌的最佳配比比例,以单因素试验和响应面设计对复合菌群HQS6513的发酵培养基和发酵条件进行优化。 结果 从马铃薯块茎中筛选出3株对马铃薯球炭疽菌(Colletotrichum coccodes)具有明显抑菌作用的菌株QS10-6、QS2-5和QS2-13,QS10-6和QS2-5鉴定为萎缩芽胞杆菌(Bacillus atrophaeus),QS2-13为贝莱斯芽胞杆菌(Bacillus velezensis);响应面法分析优化得到复合菌群HQS6513最佳发酵培养基为麸皮2.5%、酵母浸粉2.6%、NaCl 1.0%,最佳发酵条件为培养温度32 ℃、pH 5.0、接种量2.0%、摇床转速190 r/min,优化后的复合菌群HQS6513的抑菌率达到69.66%。 结论 分离得到3株芽胞杆菌,由这3株芽胞杆菌组成的复合菌群HQS6513对马铃薯球炭疽菌有高抑菌活性,在优化发酵配方和培养条件下,复合菌群HQS6513产胞量和抑菌活性增加。
罗明凯, 张豪杰, 石晖琴, 李亚楠, 封瑞超, 沈硕. 三株马铃薯炭疽病生防菌的分离鉴定及其高抑菌活性培养物发酵参数优化[J]. 生物技术通报, 2025, 41(12): 313-327.
LUO Ming-kai, ZHANG Hao-jie, SHI Hui-qin, LI Ya-nan, FENG Rui-chao, SHEN Shuo. Isolation and Identification of Biocontrol Bacteria for Potato Anthracnose in Three Strains and Optimization of Fermentation Parameters for Cultures with High Antibacterial Activity[J]. Biotechnology Bulletin, 2025, 41(12): 313-327.
菌株 Strain | 基因 Gene | GenBank 登录号 GenBank No. | 引物序列 Primer sequence (5′-3′) | 产物长度 Product size (bp) |
|---|---|---|---|---|
| QS10-6 | 16S rDNA | PQ856826 | F:TGCAGTCGAGCGGACAGATGGGA R:CACCCGAAGTCGGTGAGGTAACCT | 1 401 |
| QS2-5 | 16S rDNA | PV262563 | F:GAGCGGACAGATGGGAGCTTGCT R:CCGAAGTCGGTGAGGTAACCTTTA | 1 397 |
| QS2-13 | 16S rDNA | PQ856825 | F:GTCGAGCGGACAGATGGGAGCTTG R:TAACACCCGAAGTCGGTGAGGTAA | 1 394 |
表1 芽胞杆菌QS10-6、QS2-5、QS2-13分子鉴定的引物信息
Table 1 Primers for molecular identification of Bacillus QS10-6, QS2-5 and QS2-13
菌株 Strain | 基因 Gene | GenBank 登录号 GenBank No. | 引物序列 Primer sequence (5′-3′) | 产物长度 Product size (bp) |
|---|---|---|---|---|
| QS10-6 | 16S rDNA | PQ856826 | F:TGCAGTCGAGCGGACAGATGGGA R:CACCCGAAGTCGGTGAGGTAACCT | 1 401 |
| QS2-5 | 16S rDNA | PV262563 | F:GAGCGGACAGATGGGAGCTTGCT R:CCGAAGTCGGTGAGGTAACCTTTA | 1 397 |
| QS2-13 | 16S rDNA | PQ856825 | F:GTCGAGCGGACAGATGGGAGCTTG R:TAACACCCGAAGTCGGTGAGGTAA | 1 394 |
| 处理 Treatment | QS10-6∶QS2-5∶QS2-13 |
|---|---|
| T1 | 1∶1∶1 |
| T2 | 1∶2∶1 |
| T3 | 1∶3∶3 |
| T4 | 2∶1∶2 |
| T5 | 2∶2∶3 |
| T6 | 2∶3∶1 |
| T7 | 3∶1∶3 |
| T8 | 3∶2∶1 |
| T9 | 3∶3∶2 |
表2 3种菌株含量的比例设置
Table 2 The set ratio of the contents of three strains
| 处理 Treatment | QS10-6∶QS2-5∶QS2-13 |
|---|---|
| T1 | 1∶1∶1 |
| T2 | 1∶2∶1 |
| T3 | 1∶3∶3 |
| T4 | 2∶1∶2 |
| T5 | 2∶2∶3 |
| T6 | 2∶3∶1 |
| T7 | 3∶1∶3 |
| T8 | 3∶2∶1 |
| T9 | 3∶3∶2 |
图1 不同细菌对马铃薯炭球炭疽菌的抑菌活性A:CK;B:QS10-1;C:QS10-2;D:QS10-3;E:QS10-4;F:QS10-5;G:QS10-6;H:QS2-4;I:QS2-5;J:QS2-7;K:QS2-11;L:QS2-12;M:QS2-13;N:QS10-15;O:QS10-16;P:QS2-15;Q:QS2-17;R:QS2-19;S:QS10-18;T:QS10-19;U:QS10-20
Fig. 1 Antibacterial activities of different bacteria against Colletotrichum coccodes on potatoes
菌株 Strain | 菌落直径 Colony diameter (mm) | 抑菌率 Inhibition rate (%) |
|---|---|---|
| QS10-5 | 29.52±0.27d | 50.55±0.46c |
| QS10-6 | 34.48±0.14b | 42.25±0.24e |
| QS2-4 | 31.49±1.54c | 47.25±2.58d |
| QS2-5 | 25.82±0.16e | 56.75±0.27a |
| QS2-7 | 26.43±0.45e | 55.74±0.77b |
| QS2-11 | 29.91±0.37d | 49.91±0.06c |
| QS2-13 | 23.90±0.33f | 59.97±0.55a |
| QS10-15 | 30.25±0.12cd | 49.35±0.20cd |
| QS10-16 | 27.02±0.21e | 54.75±0.34b |
| QS2-15 | 26.67±0.13e | 55.34±0.21b |
| QS2-17 | 26.37±0.18e | 55.83±0.29b |
| QS2-19 | 26.55±0.41e | 55.53±0.07b |
| QS10-18 | 29.66±0.12d | 50.33±0.21c |
| QS10-19 | 29.48±0.27d | 50.07±0.22c |
| QS10-20 | 34.59±0.12b | 42.07±0.19e |
| CK | 59.71±0.50a |
表3 细菌抑制马铃薯炭疽病病原菌的活性
Table 3 Activities of bacteria inhibiting pathogens of potato anthracnose
菌株 Strain | 菌落直径 Colony diameter (mm) | 抑菌率 Inhibition rate (%) |
|---|---|---|
| QS10-5 | 29.52±0.27d | 50.55±0.46c |
| QS10-6 | 34.48±0.14b | 42.25±0.24e |
| QS2-4 | 31.49±1.54c | 47.25±2.58d |
| QS2-5 | 25.82±0.16e | 56.75±0.27a |
| QS2-7 | 26.43±0.45e | 55.74±0.77b |
| QS2-11 | 29.91±0.37d | 49.91±0.06c |
| QS2-13 | 23.90±0.33f | 59.97±0.55a |
| QS10-15 | 30.25±0.12cd | 49.35±0.20cd |
| QS10-16 | 27.02±0.21e | 54.75±0.34b |
| QS2-15 | 26.67±0.13e | 55.34±0.21b |
| QS2-17 | 26.37±0.18e | 55.83±0.29b |
| QS2-19 | 26.55±0.41e | 55.53±0.07b |
| QS10-18 | 29.66±0.12d | 50.33±0.21c |
| QS10-19 | 29.48±0.27d | 50.07±0.22c |
| QS10-20 | 34.59±0.12b | 42.07±0.19e |
| CK | 59.71±0.50a |

图2 菌株的菌落形态及系统发育树A:LB培养基上QS10-6的菌落形态,下同;B:QS2-5;C:QS2-13;A1:QS10-6菌株革兰氏染色形态;B1:QS2-5;C1:QS2-13;A2:基于16S rDNA、gyrA和rpoD构建的QS10-6菌株及相关基因的多基因系统发育树,下同;B2:QS2-5;C2:QS2-13
Fig. 2 Colony morphology and phylogenetic tree of strainsA: Colony morphology of QS10-6 on LB medium,the same below; B: QS2-5; C: QS2-13; A1:Gram stain morphology of strain QS10-6, the same below; B1: QS2-5; C1: QS2-13. A2: Polygenic phylogenetic tree of QS10-6 strain and related genes based on 16S rDNA, gyrA and rpoD, the same below; B2: QS2-5; C2: QS2-13
图3 溶血安全性评价A:金黄色葡萄球菌;B:QS10-6-萎缩芽胞杆菌;C:QS2-5-萎缩芽胞杆菌;D:QS2-13-贝莱斯芽胞杆菌
Fig. 3 Evaluation of hemolytic safetyA: Staphylococcus aureus; B: QS10-6-Bacillus atrophaeus; C: QS2-5-Bacillus atrophaeus; D: QS2-13- Bacillus velezensis

图4 3株活性菌相容性测定A: QS10-6 to QS2-5; B: QS10-6 to QS2-13; C: QS2-5 to QS2-13; D: QS2-5 to QS10-6; E: QS2-13 to QS10-6; F: QS2-13 to QS2-5
Fig. 4 Compatibility determination of 3 strains of active bacteria
试验 Test | 序号 Number | 处理 Treatment | 菌圈直径 Colony diameter (mm) | 抑菌率 Inhibition rate (%) |
|---|---|---|---|---|
| A:平板试验 | 1 | QS10-6 | 35.97±0.34b | 36.31±0.60e |
| 2 | QS2-5 | 24.27±0.33e | 57.04±0.58b | |
| 3 | QS2-13 | 23.54±0.19e | 58.32±0.34ab | |
| 4 | HQS65 | 28.07±0.35c | 50.29±0.63b | |
| 5 | HQS613 | 25.41±0.17d | 54.99±0.29c | |
| 6 | HQS513 | 26.18±0.32d | 53.64±0.57c | |
| 7 | HQS6513 | 23.20±0.23e | 58.91±0.42a | |
| 8 | CK | 56.48±0.71a | ||
| B:防治(发酵液) | 1 | QS10-6 | 21.41±1.28b | 23.11±4.59c |
| 2 | QS2-5 | 7.99±0.07d | 71.32 ±0.26a | |
| 3 | QS2-13 | 7.87±0.04d | 71.73±0.14a | |
| 4 | HQS65 | 10.09±0.03c | 63.77±0.11b | |
| 5 | HQS613 | 7.87±0.03d | 71.73±0.10a | |
| 6 | HQS513 | 8.06±0.03d | 71.06±0.12a | |
| 7 | HQS6513 | 7.80±0.03d | 71.99±0.09a | |
| 8 | 百菌清 | 8.11±0.03d | 70.88±0.12a | |
| 9 | 多菌灵 | 8.17±0.03d | 70.65±0.10a | |
| 10 | H2O | 7.91±0.02d | ||
| 11 | CK | 27.85±0.46a | ||
| C:防治(菌悬液) | 1 | QS10-6 | 21.10±0.26ef | 26.61±0.91c |
| 2 | QS2-5 | 20.77±0.15fj | 27.77±0.54c | |
| 3 | QS2-13 | 22.05±0.14cd | 23.31±0.49d | |
| 4 | HQS65 | 22.63±0.15c | 21.30±0.51e | |
| 5 | HQS613 | 28.45±0.06a | 1.04±0.20f | |
| 6 | HQS513 | 21.64±0.10de | 24.74±0.36d | |
| 7 | HQS6513 | 20.22±0.29j | 29.68±1.01b | |
| 8 | 百菌清 | 8.11±0.03h | 71.79±0.11a | |
| 9 | 多菌灵 | 8.17±0.03h | 71.58±0.09b | |
| 10 | H2O | 7.91±0.02h | ||
| 11 | CK | 27.85±0.46b | ||
| D:预防(发酵液) | 1 | QS10-6 | 8.29±0.09b | 71.08±0.32f |
| 2 | QS2-5 | 8.00±0.03b | 72.11±0.10c | |
| 3 | QS2-13 | 8.00±0.01 b | 72.09±0.04cd | |
| 4 | HQS65 | 8.01±0.01b | 72.06±0.04cde | |
| 5 | HQS613 | 8.12±0.02b | 71.68±0.06e | |
| 6 | HQS513 | 8.11±0.03b | 71.70±0.09de | |
| 7 | HQS6513 | 7.95±0.03b | 72.26±0.09bc | |
| 8 | 百菌清 | 7.77±0.01b | 72.89±0.04a | |
| 9 | 多菌灵 | 7.85±0.02b | 72.63±0.07ab | |
| 10 | H2O | 7.91±0.02b | ||
| 11 | CK | 28.67±0.61a | ||
| E:预防(菌悬液) | 1 | QS10-6 | 28.20±0.04a | 1.65±0.13d |
| 2 | QS2-5 | 8.31±0.38b | 71.01±1.31c | |
| 3 | QS2-13 | 8.31±0.02b | 71.00±0.07c | |
| 4 | HQS65 | 28.35±0.08a | 1.10±0.26d | |
| 5 | HQS613 | 7.99±0.16bc | 72.13±0.56bc | |
| 6 | HQS513 | 8.18±0.13bc | 71.48±0.45c | |
| 7 | HQS6513 | 8.18±0.01bc | 71.47±0.02c | |
| 8 | 百菌清 | 7.64±0.08bc | 73.34±0.29ab | |
| 9 | 多菌灵 | 7.42±0.17c | 74.13±0.58a | |
| 10 | H2O | 7.91±0.02bc | ||
| 11 | CK | 28.67±0.61a |
表4 菌株QS10-6、QS2-5、QS2-13及组成的复合菌群的抑菌活性
Table 4 Antibacterial activities of strains QS10-6, QS2-5, and QS2-13 and the composed compound microbial community
试验 Test | 序号 Number | 处理 Treatment | 菌圈直径 Colony diameter (mm) | 抑菌率 Inhibition rate (%) |
|---|---|---|---|---|
| A:平板试验 | 1 | QS10-6 | 35.97±0.34b | 36.31±0.60e |
| 2 | QS2-5 | 24.27±0.33e | 57.04±0.58b | |
| 3 | QS2-13 | 23.54±0.19e | 58.32±0.34ab | |
| 4 | HQS65 | 28.07±0.35c | 50.29±0.63b | |
| 5 | HQS613 | 25.41±0.17d | 54.99±0.29c | |
| 6 | HQS513 | 26.18±0.32d | 53.64±0.57c | |
| 7 | HQS6513 | 23.20±0.23e | 58.91±0.42a | |
| 8 | CK | 56.48±0.71a | ||
| B:防治(发酵液) | 1 | QS10-6 | 21.41±1.28b | 23.11±4.59c |
| 2 | QS2-5 | 7.99±0.07d | 71.32 ±0.26a | |
| 3 | QS2-13 | 7.87±0.04d | 71.73±0.14a | |
| 4 | HQS65 | 10.09±0.03c | 63.77±0.11b | |
| 5 | HQS613 | 7.87±0.03d | 71.73±0.10a | |
| 6 | HQS513 | 8.06±0.03d | 71.06±0.12a | |
| 7 | HQS6513 | 7.80±0.03d | 71.99±0.09a | |
| 8 | 百菌清 | 8.11±0.03d | 70.88±0.12a | |
| 9 | 多菌灵 | 8.17±0.03d | 70.65±0.10a | |
| 10 | H2O | 7.91±0.02d | ||
| 11 | CK | 27.85±0.46a | ||
| C:防治(菌悬液) | 1 | QS10-6 | 21.10±0.26ef | 26.61±0.91c |
| 2 | QS2-5 | 20.77±0.15fj | 27.77±0.54c | |
| 3 | QS2-13 | 22.05±0.14cd | 23.31±0.49d | |
| 4 | HQS65 | 22.63±0.15c | 21.30±0.51e | |
| 5 | HQS613 | 28.45±0.06a | 1.04±0.20f | |
| 6 | HQS513 | 21.64±0.10de | 24.74±0.36d | |
| 7 | HQS6513 | 20.22±0.29j | 29.68±1.01b | |
| 8 | 百菌清 | 8.11±0.03h | 71.79±0.11a | |
| 9 | 多菌灵 | 8.17±0.03h | 71.58±0.09b | |
| 10 | H2O | 7.91±0.02h | ||
| 11 | CK | 27.85±0.46b | ||
| D:预防(发酵液) | 1 | QS10-6 | 8.29±0.09b | 71.08±0.32f |
| 2 | QS2-5 | 8.00±0.03b | 72.11±0.10c | |
| 3 | QS2-13 | 8.00±0.01 b | 72.09±0.04cd | |
| 4 | HQS65 | 8.01±0.01b | 72.06±0.04cde | |
| 5 | HQS613 | 8.12±0.02b | 71.68±0.06e | |
| 6 | HQS513 | 8.11±0.03b | 71.70±0.09de | |
| 7 | HQS6513 | 7.95±0.03b | 72.26±0.09bc | |
| 8 | 百菌清 | 7.77±0.01b | 72.89±0.04a | |
| 9 | 多菌灵 | 7.85±0.02b | 72.63±0.07ab | |
| 10 | H2O | 7.91±0.02b | ||
| 11 | CK | 28.67±0.61a | ||
| E:预防(菌悬液) | 1 | QS10-6 | 28.20±0.04a | 1.65±0.13d |
| 2 | QS2-5 | 8.31±0.38b | 71.01±1.31c | |
| 3 | QS2-13 | 8.31±0.02b | 71.00±0.07c | |
| 4 | HQS65 | 28.35±0.08a | 1.10±0.26d | |
| 5 | HQS613 | 7.99±0.16bc | 72.13±0.56bc | |
| 6 | HQS513 | 8.18±0.13bc | 71.48±0.45c | |
| 7 | HQS6513 | 8.18±0.01bc | 71.47±0.02c | |
| 8 | 百菌清 | 7.64±0.08bc | 73.34±0.29ab | |
| 9 | 多菌灵 | 7.42±0.17c | 74.13±0.58a | |
| 10 | H2O | 7.91±0.02bc | ||
| 11 | CK | 28.67±0.61a |

图5 菌株QS10-6、QS2-5、QS2-13及组成的复合菌群的抑菌活性A:平板试验。a:CK;b:QS10-6;c:QS2-5;d:QS2-13;e:HQS65;f:HQS613;g:HQS513;h:HQS6513。B:菌株发酵液对马铃薯块茎(防治);C:菌株菌悬液对马铃薯块茎(防治);D:菌株发酵液对马铃薯块茎(预防);E:菌株菌悬液对马铃薯块茎(预防)。a:CK;b:H2O;c:百菌清;d:多菌灵;e:HQS6513;f:QS10-6;g:QS2-5;h:QS2-13;i:HQS65;j:HQS613;k:HQS513
Fig. 5 Antibacterial activities of strains QS10-6, QS2-5, and QS2-13 and their composite floraA: Plate test. a: CK; b: QS10-6; c: QS2-5; d: QS2-13; e: HQS65; f: HQS613; g: HQS513; h: HQS6513. B: Strain fermentation solution on potato tubers(prevention and cure). C: Strain bacterial suspension on potato tubers (prevention and cure). D: Strain fermentation solution on potato tubers (guard against). E: Strain bacterial suspension on potato tubers (guard against). a: CK; b: H2O; c: Chlorothalonil; d: carbendazim; e: HQS6513; f: QS10-6; g: QS2-5; h: QS2-13; i: HQS65; j: HQS613; k: HQS513

图7 不同培养基组分及其浓度对复合菌群HQS6513生长和抑菌活性的影响柱状图:处理后复合菌群HQS6513发酵液的OD600;折线:处理后复合菌群HQS6513的抑菌率;图柱或折线上不同小写字母表示差异显著(P<0.05)。下同
Fig. 7 Effects of different medium components and their concentrations on the growth and antibacterial activity of complex flora HQS6513Column chart: OD600 of complex bacterial group HQS6513 fermentation solution after treatment. Broken line: Inhibition rate of complex bacteria HQS6513 after treatment. Different lowercase letters on the column or line indicate significant difference (P<0.05). The same below
编号 Number | 麸皮(A) Bran (A) | 酵母浸粉(B) Yeast extract powder (B) | NaCl(C) | OD600 | 抑菌率 Inhibition rate (%) |
|---|---|---|---|---|---|
| 1 | 2.0 | 2.0 | 1.0 | 3.021 | 54.99 |
| 2 | 3.0 | 2.0 | 1.0 | 3.162 | 55.17 |
| 3 | 2.0 | 3.0 | 1.0 | 3.174 | 57.23 |
| 4 | 3.0 | 3.0 | 1.0 | 3.213 | 56.41 |
| 5 | 2.0 | 2.5 | 0.5 | 2.972 | 56.31 |
| 6 | 3.0 | 2.5 | 0.5 | 3.051 | 56.18 |
| 7 | 2.0 | 2.5 | 1.5 | 3.113 | 57.64 |
| 8 | 3.0 | 2.5 | 1.5 | 3.072 | 56.52 |
| 9 | 2.5 | 2.0 | 0.5 | 3.085 | 56.68 |
| 10 | 2.5 | 3.0 | 0.5 | 3.126 | 56.72 |
| 11 | 2.5 | 2.0 | 1.5 | 3.159 | 56.32 |
| 12 | 2.5 | 3.0 | 1.5 | 3.132 | 58.56 |
| 13 | 2.5 | 2.5 | 1.0 | 3.157 | 63.78 |
| 14 | 2.5 | 2.5 | 1.0 | 3.156 | 63.26 |
| 15 | 2.5 | 2.5 | 1.0 | 3.148 | 63.57 |
| 16 | 2.5 | 2.5 | 1.0 | 3.162 | 63.97 |
| 17 | 2.5 | 2.5 | 1.0 | 3.168 | 63.48 |
表5 复合菌群HQS6513发酵培养基组分优化试验的因素和水平
Table 5 Factors and levels of optimized test for fermentation medium components of complex flora HQS6513
编号 Number | 麸皮(A) Bran (A) | 酵母浸粉(B) Yeast extract powder (B) | NaCl(C) | OD600 | 抑菌率 Inhibition rate (%) |
|---|---|---|---|---|---|
| 1 | 2.0 | 2.0 | 1.0 | 3.021 | 54.99 |
| 2 | 3.0 | 2.0 | 1.0 | 3.162 | 55.17 |
| 3 | 2.0 | 3.0 | 1.0 | 3.174 | 57.23 |
| 4 | 3.0 | 3.0 | 1.0 | 3.213 | 56.41 |
| 5 | 2.0 | 2.5 | 0.5 | 2.972 | 56.31 |
| 6 | 3.0 | 2.5 | 0.5 | 3.051 | 56.18 |
| 7 | 2.0 | 2.5 | 1.5 | 3.113 | 57.64 |
| 8 | 3.0 | 2.5 | 1.5 | 3.072 | 56.52 |
| 9 | 2.5 | 2.0 | 0.5 | 3.085 | 56.68 |
| 10 | 2.5 | 3.0 | 0.5 | 3.126 | 56.72 |
| 11 | 2.5 | 2.0 | 1.5 | 3.159 | 56.32 |
| 12 | 2.5 | 3.0 | 1.5 | 3.132 | 58.56 |
| 13 | 2.5 | 2.5 | 1.0 | 3.157 | 63.78 |
| 14 | 2.5 | 2.5 | 1.0 | 3.156 | 63.26 |
| 15 | 2.5 | 2.5 | 1.0 | 3.148 | 63.57 |
| 16 | 2.5 | 2.5 | 1.0 | 3.162 | 63.97 |
| 17 | 2.5 | 2.5 | 1.0 | 3.168 | 63.48 |
方差来源 Variance source | 平方和 Quadratic sum | 自由度 Degree of freedom | 均方 Mean square | F | P | 显著性 Significance |
|---|---|---|---|---|---|---|
| 模型 Model | 185.59 | 9 | 20.62 | 272.09 | <0.000 1 | ** |
| 麸皮(A) Bran | 0.446 5 | 1 | 0.446 5 | 5.89 | 0.0456 | * |
| 酵母浸粉(B) Yeast extract powder | 4.15 | 1 | 4.15 | 54.72 | 0.0001 | ** |
| NaCl(C) | 1.24 | 1 | 1.24 | 16.37 | 0.004 9 | * |
| AB | 0.250 0 | 1 | 0.25 | 3.3 | 0.112 2 | |
| AC | 0.245 0 | 1 | 0.245 | 3.23 | 0.115 2 | |
| BC | 1.21 | 1 | 1.21 | 15.97 | 0.005 2 | * |
| A2 | 68.54 | 1 | 68.54 | 904.44 | <0.000 1 | ** |
| B2 | 55.40 | 1 | 55.4 | 730.97 | <0.000 1 | ** |
| C2 | 35.77 | 1 | 35.77 | 472.01 | <0.000 1 | ** |
| 残差 Residual | 0.530 5 | 7 | 0.075 8 | |||
| 失拟项 Lack of fit | 0.231 0 | 3 | 0.077 | 1.03 | 0.469 3 | |
| 纯误差 Pure error | 0.299 5 | 4 | 0.074 9 | |||
| 总误差 Cor total | 186.12 | 16 | ||||
| R2=0.9971;R2adj=0.9935;Adeq precision=39.7638 | ||||||
表6 复合菌群HQS6513培养基组分优化的回归模型显著性检验
Table 6 Significance test of regression model for component optimization of complex flora HQS6513 medium
方差来源 Variance source | 平方和 Quadratic sum | 自由度 Degree of freedom | 均方 Mean square | F | P | 显著性 Significance |
|---|---|---|---|---|---|---|
| 模型 Model | 185.59 | 9 | 20.62 | 272.09 | <0.000 1 | ** |
| 麸皮(A) Bran | 0.446 5 | 1 | 0.446 5 | 5.89 | 0.0456 | * |
| 酵母浸粉(B) Yeast extract powder | 4.15 | 1 | 4.15 | 54.72 | 0.0001 | ** |
| NaCl(C) | 1.24 | 1 | 1.24 | 16.37 | 0.004 9 | * |
| AB | 0.250 0 | 1 | 0.25 | 3.3 | 0.112 2 | |
| AC | 0.245 0 | 1 | 0.245 | 3.23 | 0.115 2 | |
| BC | 1.21 | 1 | 1.21 | 15.97 | 0.005 2 | * |
| A2 | 68.54 | 1 | 68.54 | 904.44 | <0.000 1 | ** |
| B2 | 55.40 | 1 | 55.4 | 730.97 | <0.000 1 | ** |
| C2 | 35.77 | 1 | 35.77 | 472.01 | <0.000 1 | ** |
| 残差 Residual | 0.530 5 | 7 | 0.075 8 | |||
| 失拟项 Lack of fit | 0.231 0 | 3 | 0.077 | 1.03 | 0.469 3 | |
| 纯误差 Pure error | 0.299 5 | 4 | 0.074 9 | |||
| 总误差 Cor total | 186.12 | 16 | ||||
| R2=0.9971;R2adj=0.9935;Adeq precision=39.7638 | ||||||

图8 不同培养基组分的交互作用对复合菌群HQS6513抑菌活性影响的等高线及响应面图A、D:麸皮与酵母浸粉交互作用;B、E:麸皮与NaCl交互作用;C、F:酵母浸粉与NaCl交互作用
Fig. 8 Effects of interaction of different medium components on antibacterial activity of complex flora HQS6513: Contour and response surfaceA, D: Interaction between bran and yeast extract powder. B, E: Interaction between bran and NaCl. C, F: Interaction between yeast extract powder and NaCl
| [1] | 李统华. 马铃薯炭疽菌生防细菌的筛选、鉴定及发酵工艺优化 [D]. 兰州: 甘肃农业大学, 2022. |
| Li TH. Screening and identification of Colletotrichum coccodes bacteria and optimization offermentation process [D]. Lanzhou: Gansu Agricultural University, 2022. | |
| [2] | Das R, Jha KK, Baveesh P, et al. Entrepreneurial behaviour determinants of potato farmers: evidence from northeastern states of India [J]. Potato Res, 2024: 9837. |
| [3] | Yang T, Sun HB, Shen CC, et al. Fungal assemblages in different habitats in an erman’s birch forest [J]. Front Microbiol, 2016, 7: 1368. |
| [4] | 郭海. 解淀粉芽胞杆菌262AG6对马铃薯炭疽病菌抑菌活性分析以及发酵工艺研究 [D]. 兰州: 甘肃农业大学, 2018. |
| Guo H. Analysis the antagonistic mechanism of Bacillus amyloliquefaciens 262AG6 against Colletotrichum coccodes and optimization its fermentation process [D]. Lanzhou: Gansu Agricultural University, 2018. | |
| [5] | 金梦军, 杨成德, 李统华, 等. 细胞壁降解酶在球刺盘孢侵染过程中的作用 [J]. 植物保护, 2024, 50(3): 88-98, 110. |
| Jin MJ, Yang CD, Li TH, et al. The role of cell wall-degrading enzymes of Colletotrichum coccodes during its infection [J]. Plant Prot, 2024, 50(3): 88-98, 110. | |
| [6] | 展莉平, 任雪洋, 张笑一, 等. 基于FUNGuild的山药腐烂块茎真菌群落研究及潜在病原真菌的分离鉴定 [J]. 广西植物, 2025, 45(2): 347-359. |
| Zhan LP, Ren XY, Zhang XY, et al. FUNGuild-based study of fungal community, and isolation and identification of potential pathogenic fungi in yam (Dioscorea polystachya) rotting tubers [J]. Guihaia, 2025, 45(2): 347-359. | |
| [7] | 金梦军. 球炭疽菌果胶酶候选效应蛋白的筛选、鉴定及其功能研究 [D]. 兰州: 甘肃农业大学, 2023. |
| Jin MJ. Screening, identification of pectinase candidate effectors from Colletotrichum coccodes and their functional analysis [D]. Lanzhou: Gansu Agricultural University, 2023. | |
| [8] | 栋文琴, 字雨欣, 邢海波, 等. 冬马铃薯主要病虫害绿色防控措施 [J]. 云南农业, 2017(1): 39-41. |
| Dong WQ, Zi YX, Xing HB, et al. Green prevention and control measures of main diseases and insect pests of winter potato [J]. Yunnan Agric, 2017(1): 39-41. | |
| [9] | Zhong LY, Li LH, Zheng YL, et al. First report of black dot caused by Colletotrichum coccodes on potato in the Tibet Autonomous Region of China [J]. Plant Dis, 2022, 106(10): 2746. |
| [10] | Pérez-Mora JL, Cota-Rodríguez DA, Rodríguez-Palafox EE, et al. First confirmed report of Colletotrichum coccodes causing black dot on potato in Mexico [J]. J Plant Dis Prot, 2020, 127(2): 269-273. |
| [11] | 惠娜娜, 王立, 郑果, 等. 8种杀菌剂对马铃薯炭疽病病菌室内毒力测定 [J]. 甘肃农业科技, 2021, 52(4): 22-24. |
| Hui NN, Wang L, Zheng G, et al. Indoor virulence determination of eight kinds of fungicides to potato anthracnose germs [J]. Gansu Agric Sci Technol, 2021, 52(4): 22-24. | |
| [12] | 魏立娟. 枯草芽孢杆菌(Bacillus subtilis)ZA1S代谢物对球炭疽菌(Colletotrichum coccodes)的抑菌机制研究 [D]. 兰州: 甘肃农业大学, 2023. |
| Wei LJ. The mechanism of inhibition of Bacillus subtilis ZAlS metabolites against Colletotrichum coccodes [D]. Lanzhou: Gansu Agricultural University, 2023. | |
| [13] | 吴慧芳, 蒙耀, 石晖琴, 等. 一株马铃薯干腐病生防菌的鉴定及其抑菌活性研究 [J]. 植物保护, 2024, 50(3): 111-120. |
| Wu HF, Meng Y, Shi HQ, et al. Identification of a biocontrol bacterium against potato dry rot and its antibacterial activity [J]. Plant Prot, 2024, 50(3): 111-120. | |
| [14] | 李嘉慧, 刘茂林, 李梓诺, 等. 拮抗微生物对樱桃采后病害生物防治的研究进展 [J]. 食品安全质量检测学报, 2024, 15(17): 135-143. |
| Li JH, Liu ML, Li ZN, et al. Progress of research on biological control of cherry postharvest diseases by antagonistic microorganisms [J]. J Food Saf & Qual, 2024, 15(17): 135-143. | |
| [15] | 张雨雨, 高晨, 董雅芹, 等. 萎缩芽孢杆菌CY1对马铃薯疮痂病的防治效果和抑菌机理初探 [J]. 安徽工程大学学报, 2024, 39(4): 9-15. |
| Zhang YY, Gao C, Dong YQ, et al. A preliminary study on the effect of Bacillus atrophaeus CY1 on the control of potato common scab and the mechanism of bacterial inhibition [J]. J Anhui Polytech Univ, 2024, 39(4): 9-15. | |
| [16] | 李昊宇, 李爱珍, 王娅婷, 等. 马铃薯枯萎病拮抗细菌的分离及生测评价 [J]. 青岛农业大学学报: 自然科学版, 2025, 42(1): 1-6, 13. |
| Li HY, Li AZ, Wang YT, et al. Isolation and bioassay evaluation of antagonistic bacteria against potato Fusarium wilt [J]. J Qingdao Agric Univ Nat Sci, 2025, 42(1): 1-6, 13. | |
| [17] | 马浩天, 李杨, 余梦博, 等. 产细菌素贝莱斯芽孢杆菌CM7-4全基因组测序及抑菌活性研究 [J]. 中国畜牧兽医, 2024, 51(12): 5117-5127. |
| Ma HT, Li Y, Yu MB, et al. Whole genome sequencing of bacteriocin-producing Bacillus velezensis CM7-4 and its bacteriostatic activity [J]. China Anim Husb Vet Med, 2024, 51(12): 5117-5127. | |
| [18] | 宁辛. 玉米苗枯病病原鉴定及其生物防控 [D]. 泰安: 山东农业大学, 2024. |
| Ning X. Pathogen identification and biological control of maize seedling bligh [D]. Tai’an: Shandong Agricultural University, 2024. | |
| [19] | 李展博. 胶红酵母JAASRY-1固态发酵工艺优化及应用研究 [D]. 长春: 吉林农业大学, 2024. |
| Li ZB. Optimization and application research of solid-state fermentation process of rhodotorula glutinis JAASRY-1 [D]. Changchun: Jilin Agricultural University, 2024. | |
| [20] | 高媛, 孟祥才, 刘秀波, 等. 防治人参黑斑病与灰霉病的复合芽孢杆菌制剂 [J]. 东北林业大学学报, 2022, 50(2): 106-109, 116. |
| Gao Y, Meng XC, Liu XB, et al. Bacillus bacteria preparation for preventing and controlling Alternaria panax and bolrytis elliptica of Panax ginseng [J]. J Northeast For Univ, 2022, 50(2): 106-109, 116. | |
| [21] | 汤伟, 王祺, 张军, 等. 耐低温降解菌Bacillus mobilis10的生物学特性及其对海参养殖水质的净化作用 [J]. 水产科学, 2024, 43(6): 885-893. |
| Tang W, Wang Q, Zhang J, et al. Biological characteristics and application in water purification in sea cucumber culture ponds in cryotolerant degrading bacterium strain Bacillus mobilis 10 [J]. Fish Sci, 2024, 43(6): 885-893. | |
| [22] | 林航航, 赵昕宇, 王林惠, 等. 芒果细菌性角斑病的防治技术研究 [J]. 中国生物防治学报, 2024, 40(6): 1439-1446. |
| Lin HH, Zhao XY, Wang LH, et al. Technology of preventing and controlling mango bacterial leaf spot [J]. Chin J Biol Control, 2024, 40(6): 1439-1446. | |
| [23] | 东秀珠, 蔡妙英. 常见细菌系统鉴定手册 [M]. 北京: 科学出版社, 2001. |
| Dong XZ, Cai MY. Handbook of identification of common bacterial systems [M]. Beijing: Science Press, 2001. | |
| [24] | 单良豪. 复合乳酸菌发酵白萝卜汁品质研究 [D]. 锦州: 渤海大学, 2024. |
| Shan LH. Research on the quality of fermented white radish juice by composite lactic acid bacteria [D]. Jinzhou: Bohai University, 2024. | |
| [25] | 汪苏洁, 顾梦丽, 陶界锰, 等. 烟草疫霉拮抗菌XC-29的分离鉴定及其全基因组序列分析 [J]. 生物技术进展, 2024, 14(6): 1004-1015. |
| Wang SJ, Gu ML, Tao JM, et al. Isolation, identification and whole-genome sequence analysis of Phytophthora nicotianae antagonistic bacteria XC-29 [J]. Curr Biotechnol, 2024, 14(6): 1004-1015. | |
| [26] | 刘建春, 舒灿伟, 刘丽, 等. 烟草叶片内生细菌分离鉴定及抑菌与促生效果评价 [J]. 烟草科技, 2025, 58(2): 65-75, 112. |
| Liu JC, Shu CW, Liu L, et al. Isolation and identification of endophytic bacteria from tobacco leaves and evaluation of their antibacterial and growth-promoting effects [J]. Tob Sci Technol, 2025, 58(2): 65-75, 112. | |
| [27] | 李宁健, 江玉玲, 安雪姣, 等. 一组高效喹啉降解复合菌群的构建及其降解特性 [J]. 微生物学通报, 2023, 50(6): 2305-2319. |
| Li NJ, Jiang YL, An XJ, et al. Screening and biodegradation characteristics of an efficient quinoline-degrading microbial consortium [J]. Microbiol China, 2023, 50(6): 2305-2319. | |
| [28] | 陈燕鸿, 蔺红苹, 徐苏琪, 等. 植物根际促生菌的筛选及其耐盐促生效果 [J]. 微生物学报, 2025, 65(1): 150-168. |
| Chen YH, Lin HP, Xu SQ, et al. Screening of plant growth-promoting rhizobacterium with salt tolerance from rhizosphere [J]. Acta Microbiol Sin, 2025, 65(1): 150-168. | |
| [29] | 徐小雯, 张红云, 林南新, 等. 牛源芽孢杆菌的分离鉴定和益生特性分析 [J]. 动物营养学报, 2025, 37(8): 5645-5656. |
| Xu XW, Zhang HY, Lin NX, et al. Isolation, identification and probiotic properties analysis of Bacillus from bovine [J]. Chin J Anim Nutr, 2025, 37(8): 5645-5656. | |
| [30] | 李有玉. 棘孢木霉对三七促生防病作用的机理研究 [D]. 昆明: 昆明理工大学, 2024. |
| Li YY. Study on the mechanism of Trichoderma acanthoides on promoting growth and preventing diseases of Panax notoginseng [D]. Kunming: Kunming University of Science and Technology, 2024. | |
| [31] | 吴卓颖, 邵威平, 张永玲, 等. 重组枯草芽孢杆菌发酵产青霉素G酰化酶的条件优化 [J]. 甘肃农业大学学报, 2016, 51(2): 116-126. |
| Wu ZY, Shao WP, Zhang YL, et al. Optimization of fermentation for Penicillin G acylase with recombinant Bacillus megaterium [J]. J Gansu Agric Univ, 2016, 51(2): 116-126. | |
| [32] | 蒙耀, 陈红雨, 吴慧芳, 等. 响应面法优化生防暹罗芽孢杆菌JZ1-4-10的发酵参数 [J]. 南方农业学报, 2024, 55(6): 1671-1681. |
| Meng Y, Chen HY, Wu HF, et al. Optimization of fermentation parameters against Bacillus siamensis JZ1-4-10 by response surface method [J]. J South Agric, 2024, 55(6): 1671-1681. | |
| [33] | 刘爽, 江洲, 赵帅, 等. 一株产蛋白酶细菌的筛选、鉴定及发酵工艺优化 [J]. 生物技术通报, 2025, 41(4): 335-344. |
| Liu S, Jiang Z, Zhao S, et al. Screening, identification, and fermentation optimization of a protease-producing bacterial strain [J]. Biotechnol Bull, 2025, 41(4): 335-344. | |
| [34] | 张评美, 陶禹, 彭宇翔, 等. 响应面法优化贝莱斯芽孢杆菌XY40-1发酵条件 [J]. 湖南农业科学, 2024(9): 1-7. |
| Zhang PM, Tao Y, Peng YX, et al. Optimization of fermentation conditions of Bacillus velezensis XY40-1 by response surface methodology [J]. Hunan Agric Sci, 2024(9): 1-7. |
| [1] | 吕镇, 甘恬, 霍思羽, 赵晨笛, 赵梦瑶, 李亚涛, 马玉超, 耿玉清. 产Surfactin贝莱斯芽胞杆菌C5A-1的鉴定和所产Surfactin对植物的促生效果[J]. 生物技术通报, 2025, 41(9): 265-276. |
| [2] | 石艳华, 李朔, 高玉珠, 郑保坤, 朱杰华, 张岱, 杨志辉. 贝莱斯芽胞杆菌NZ-4挥发性有机物的促生作用及其活性成分分析[J]. 生物技术通报, 2025, 41(8): 300-310. |
| [3] | 张津浩, 邓辉, 张清壮, 陶禹, 周池, 李鑫. 贝莱斯芽胞杆菌XY40-1对百合球茎生长、品质及镉含量的调控作用[J]. 生物技术通报, 2025, 41(7): 281-291. |
| [4] | 刘爽, 江洲, 赵帅, 赵雷真, 黄峰, 周佳, 屈建航. 一株产蛋白酶细菌的筛选、鉴定及发酵工艺优化[J]. 生物技术通报, 2025, 41(4): 335-344. |
| [5] | 吕济敏, 刘巍, 孙敏, 李洪顺, 彭振兴, 邱鹏飞, 朱其立. 马铃薯早疫病拮抗菌的筛选鉴定和发酵条件优化[J]. 生物技术通报, 2025, 41(10): 175-185. |
| [6] | 刘倩, 马连杰, 张慧, 王冬, 范茂, 廖敦秀, 赵正武, 卢文才. 辣椒炭疽病生防菌株TN2的筛选鉴定与抑菌效果[J]. 生物技术通报, 2025, 41(1): 287-297. |
| [7] | 常海霞, 李明源, 麦日艳古·亚生, 周茜, 王继莲. 产胞外多糖多功能促生菌的筛选鉴定及促生评价[J]. 生物技术通报, 2024, 40(3): 273-285. |
| [8] | 余金岂, 邬柯奕, 陈正睿, 王婧涵, 张鑫, 王春月. 珊瑚状猴头菌多糖超声辅助提取工艺优化及抗结直肠癌活性研究[J]. 生物技术通报, 2024, 40(11): 78-87. |
| [9] | 涂晓媛, 褚路路, 王冕, 陈炳智, 江玉姬. 珊瑚状猴头菇多糖的提取及其体外抗氧化活性分析[J]. 生物技术通报, 2023, 39(12): 276-286. |
| [10] | 张秀民, 马绍英, 杨洁, 包金玉, 张晓玲, 田鹏, 路亚琦, 李胜. 以次生代谢物产量为目标的西兰花毛状根培养技术体系优化[J]. 生物技术通报, 2021, 37(8): 75-84. |
| [11] | 罗素亚, 郑豆豆, 何广正, 张琳琳, 徐书景, 鞠建松. 响应面法优化脯氨酸羟化酶转化反应工艺条件[J]. 生物技术通报, 2020, 36(6): 157-164. |
| [12] | 武利勤, 尚宏忠, 顾海科. 拮抗匍枝根霉的生防菌R1B的筛选鉴定和抑菌活析[J]. 生物技术通报, 2019, 35(4): 29-35. |
| [13] | 王玉杰, 王湘君. 响应面法优化改性香蕉皮对Pb2+的吸附研究[J]. 生物技术通报, 2019, 35(4): 188-194. |
| [14] | 麻金金, 葛蓓孛, 施李鸣, 刘炳花, 韦秋合, 张克诚. 玫瑰黄链霉菌NKZ-259发酵培养基的优化[J]. 生物技术通报, 2019, 35(2): 85-92. |
| [15] | 左振宇, 喻放, 黄艳鸿, 王家怡, 李凌凌. 蚕蛹超声辅助常温脱脂工艺条件优化[J]. 生物技术通报, 2016, 32(2): 158-164. |
| 阅读次数 | ||||||
|
全文 |
|
|||||
|
摘要 |
|
|||||